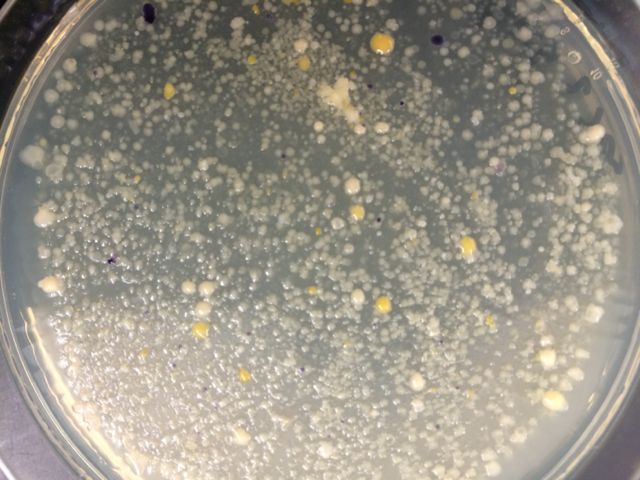

User:Alexandra A. Taylor/Notebook/Biology 210 at AU
March 4, 2015: Embryology & Zebra Fish Development II
Purpose
The purpose of this lab was to observe any changes in our zebra fish control and experimental treatments. In addition to the observations performed in class today, further observations were made every 1-2 days, during which time the water was also changed. We hypothesized that the fish raised in ethanol would have a smaller eye diameter and smaller body length than the control fish, as found in the Bilotta study. We also expected to see differences in behavior in the experimental fish compared with the control.
Materials & Methods
A transfer pipette was used to clean debris and cast-off egg shells from the water. A dissection scope was used to observe the dishes, and then depression slides and a compound microscope were used to observe the fish individually. Heart rate was measured by counting beats for 30 seconds and then multiplying by 2, when a heart rate was visible. The ocular micrometer of the compound microscope was used to measure both body size and eye size.
Data & Observations
Data from several days worth of observations are detailed below. As of Monday, no further observations were possible because of an accident in the communal storage space which compromised the majority of the specimens.
Friday, February 20
Control
Eye size: .242 mm
Body length: 1.17 mm (egg)
Heart rate: 72 bpm (one visible)
Movement: Not moving, but flowing motion visible within eggs
Color: Greenish/purple pigment scattered throughout, black eyes
Experimental
Eye size: .217 mm
Body length: 1.103 mm (egg)
Heart rate: 98 bpm (one visible)
Movement: Not moving, but flowing motion visible within eggs
Color: Black/gray coloration, black eyes

Monday, February 23
Control
Eye size:.450 mm
Body length: 3.375 mm
Heart rate: Moved too fast to calculate
Movement: Zipped around, moved quickly
Color change: None
Experimental
Eye size: .450 mm
Body length: 3.313 mm
Heart rate: Moved too fast to calculate
Movement: Not all moved, some remained stable and others zipped around quickly
Color change: None
Wednesday, February 25
Control
15 live fish remaining
Eye size: .438 mm
Body length: 2.875 mm
Heart rate: not visible
Movement: Fast movement, one having trouble moving
Color: Dark pigment dots scattered throughout body, transparent
Eye shape: round
Experimental
14 live fish remain
Eye size: .438 mm
Body length: 3.375 mm
Heart rate: not visible
Movement: Similar, fast movement observed
Color: Greenish yellow as opposed to transparent, dark pigment scattered
Eye shape: bean-shaped
Monday, March 2
Control
All fish have died
Eye size: Not visible
Body length: 4.125 mm
Heart rate: none
Movement: none
Color: colorless
Experimental
Eye size: Not visible
Body length: 4.375
Heart rate: none
Movement: none
Color: colorless


Conclusions & Future Directions
The hypothesis for the experiment was not met. As is evident from the graphs, the experimental fish had neither smaller body or eye size as expected. Unfortunately the scope of the study was not significant enough to draw any conclusions, since there was some data missing and neither treatment survived the entire course of the experiment. It remains likely that the hypothesis would have been met, had more data been collected. However, the experimental fish did exhibit some more erratic behavior than the control fish, which may have been one consequence of their being raised in the ethanol solution.
February 20, 2015: Vertebrates
Purpose
The purpose of this lab was to observe the transect to discover what types of invertebrates might be living in it or passing through. We expected to see a few animals, although not as many as might be present in warmer months.
Materials & Methods
We performed the observation from the bench located in the center of the transect. Once the organisms had been observed, we combined this data with all of the other data we had collected on organisms from different kingdoms to determine how the feeding habits of each organism linked it to all the others.
Data & Observations
-Squirrels. There are a lot of gray squirrels on campus at any given time, and our transect is no exception. Black squirrels can also sometimes be seen from time to time. Squirrels are foragers who collect nuts and seeds and store them over the winter.
-Birds. Once small black bird was identified as potentially being a starling. It is likely that many more birds would be drawn to the transect based on the availability of trees and shrubs for feeding and cover. Starlings are omnivores and will feed on insects as well as berries, seeds, and nuts.
-Humans. Our habitat is man-made and is centrally located on the University’s campus, so there is a strong human presence both from foot traffic and from the upkeep and landscaping of the transect. While humans do not eat any of the animals in the transect in the world as it exists today, humans would still be considered to be at the top of the food chain, being omnivorous and having superior hunting skills.
-Mice & rats. Although no mice or rats were found specifically in the transect, there is a large population of each on campus and the likelihood is high that they would pass through the transect from time to time. Rats are scavengers and will eat a wide range of foods; mice are primarily herbivores, but are known to expand their eating habits in urban environments.
Conclusions & Future Directions
As shown in the above food web, there is a strong connection between the small percentage of organisms that were unearthed in this study. One change in the populations of one of these species could have an effect at every level of the food web. There is also a sense of the interconnectedness of this transect with the larger AU campus and DC as a whole, since these organisms, especially the vertebrates, are not tied to this transect but travel between this and other environments at will.
February 18: Embryology & Zebra Fish Development I
Purpose
The purpose of the first part of this lab was to compare the sequences obtained from our PCR samples to the NCBI blast database. Afterwards, we chose an experimental treatment for our zebra fish embryos and selected embryos for the control and experimental dishes.
Materials & Methods
For the sequencing, we used the NCBI BLAST website to compare the sequences obtained from the Genewiz website to the known sequences of other organisms’ DNA. We entered the sequences, ran a nucleotide blasts, and found the corresponding genus & species with the highest level of accuracy.
To set up the zebra fish experiment, first we chose the experimental treatment. We decided to use the same treatment that was studied in the article we presented on, which was ethanol. We set up two dishes, a control with Deer Park water and an experimental dish with 1.5% ethanol solution. We carefully selected 20 eggs for each dish using a transfer pipette, looking for eggs that were translucent and healthy-looking. After planning out our observation table, we affixed the lids to the dishes with tape and stored them in the class bin.
Data & Observations
The results for the NCBI sequences are below. The gels from the original PCR trial can be seen below.
MB7
>MB76-Rev_16S_G01.ab1
NNNNNNNNNGNNNNNNNNNNNNNNNCTCNTGTNACGGTNNNNNACTTCAGGTACCCCAGACTTCCATGGCTTGACGGGCG
GTGTGTACAAGGCCCGGGAACGTATTCACCGCGCCATGGCTGATGCGCGATTACTAGCGATTCCAGCTTCATAGAGTCGA
GTTGCAGACTCCAATCCGAACTGAGACCGGCTTTCGAGATTCGCATCACATCGCTGTGTAGCTGCCCTCTGTACCGGCCA
TTGTATTACGTGTGTGGCCCAAGGCGTAAGGGCCGTGATGATTTGACGTCATCCCCACCTTCCTCTCTACTTGCGTAGGC
AGTCTCACTAGAGTCCCCAACTTAATGATGGCAACTAGTGACAGGGGTTGCGCTCGTTGCAGGACTTAACCTAACACCTC
ACGGCACGAGCTGACGACAACCATGCAGCACCTTGAAAAATGTCCGAAGAAAAGTCTATTTCTAAACCTGTCATTTCCCA
TTTAAGCCTTGGTAAGGTTCCTCGCGTATCATCGAATTAAACCACATAATCCACCGCTTGTGCGGGCCCCCGTCAATTCC
TTTGAGTTTCAGACTTGCGTCCGTACTCCCCAGGTGGCTAACTTATCACTTTCGCTTAGTCTCTGAATCCGAAAACCCAA
AAACGAGTTAGCATCGTTTACGGCGTGGACTACCAGGGTATCTAATCCTGTTCGCTCCCCACGCTTTCGTCCATCAGCGT
CAGTTGTTGCTTAGTAACCTGCCTTCGCAATTGGTGTTCTAAGTAATATCTATGCATTTCACCGCTACACTACTTATTCC
AGCTACTTCAACAACACTCAAGACTTGCAGTATCAATGGCAGTTTCACAGTTAAGCTGTGAGATTTCACCACTGACTTAC
AAATCCGCCTACGGACCCTTTAAACCCAATAAATCCCGGATAACGCTTGCACCCTCCGTATTACCGCGGCTGCTGGCACG
GGAGTTAGCNNNGCTTANTCGTATAGTACCTTCAGCTAGATACACGTANNTNGGTTTATCCCTATACAAAGAAGTTTANN
NCCATNNNNNNNCCTTCANGCNGATGGCTGGATCNNNNNTCACCCATTNNCCAANANTNCNTCACTGCNNN
Chryseobacterium jejeunse: aerobic, Gram-negative, non-motile, yellow-pigmented, straight rod-shaped bacteria (Wikipedia). Other equal matches, different species of chyseobacterium.
MB8
>MB77-Rev_16S_H01.ab1
NNNNNNNNNNNNNNNNNNNNNNNNNNNNNNNNCNNNNNNNNNNANNNTNNNNCTACTTCTGGTAAAACCCGCTCCCATGG
TGTGACGGGCGGTGTGTACAAGACCCGGGAACGTATTCACCGCGACATGCTGATCCGCGATTACTAGCGATTCCAACTTC
ATGCAGTCGAGTTGCAGACTACAATCCGGACTACGATACACTTTCTGCGATTAGCTCCCCCTCGCGGGTTGGCGGCGCTC
TGTATGTACCATTGTATGACGTGTGAAGCCCTACCCATAAGGGCCATGAGGACTTGACGTCATCCCCACCTTCCTCCGGT
TTGTCACCGGCAGTCTCATTAGAGTGCCCTTTCGTAGCAACTAATGACAAGGGTTGCGCTCGTTGCGGGACTTAACCCAA
CATCTCACGACACGAGCTGACGACAGCCATGCAGCACCTGTGTACTGGTTCTCTTTCGAGCACTCCCCGATCTCTCGGGG
ATTCCAGCCATGTCAAGGGTAGGTAAGGTTTTTCGCGTTGCATCGAATTAATCCACATCATCCACCGCTTGTGCGGGTCC
CCGTCAATTCCTTTGAGTTTTAATCTTGCGACCGTACTCCCCAGGCGGTCTACTTCACGCGTTAGCTGCGTTACCAAGTC
AATTAAGACCCGACAACTAGTAGACATCGTTTAGGGCGTGGACTACCAGGGTATCTAATCCTGTTTGCTCCCCACGCTTT
CGTGCATGAGCGTCAATCTTGACCCANGGGGCTGCCTTCGCCATCGGTGTTCCTCCACATATCTACGCATTTCACTGCTA
CACGTGGAATTCTACCCCCCTCTGCCAGATTCTAGCCTTGCAGTCTCCAATGCAATTCCCAGGTTGAGCCCGGGGATTTC
ACATCANACTTACAAAACCGCCNGCGCACGCTTNACGCCCAGTAATTCCGANTAACGCTTGCACCCTACGTATTACCGCG
GCTGCTGGCACGTAGTTAGCCNGTGCTTANNNNTCNNNACCGTCATTAGCANAGANATAGCTCTCANCNTTTCNTCCCNG
ANAAAGAGCTTTANANCCGAANNNTCTTCANNCNNGCGNATTGNTGGATCAGGNTTTCNC
Janthinobacterium lividum: aerobic, Gram-negative, soil-dwelling, dark-violet bacterium (Wikipedia). Other equal matches, different species of janthinobacterium.
Our hypothesis for the zebra fish experiment was that the experimental fish would exhibit developmental malformations, including decreased body size, decreased eye size, and increased space between eyes, compared with the control fish.
Conclusions & Future Directions
The janthinobacterium lividum was identified as the sample taken from the non-tet plate at a 10-5 dilution. We had marked it as Gram-positive, although the janthinobacterium are Gram-negative. The chryseobacterium were not examined under the microscope or stained with Gram stain, but they are easily identifiable in the photos as surviving best on the tetracycline-treated plates.
February 11: Invertebrates
Purpose
The purpose of this lab was to introduce us to the variability & complexity of invertebrates. We started out observing invertebrates in the lab and then moved onto our Burlese funnels that we had set up last week.
Materials & Methods
First we observed live invertebrates with the dissecting scopes. The planaria were thick, scrunched-up bluish-black worms that remained dormant unless agitated for the most part. The nematodes were thin, small, clear worms that exhibited a constant undulating or wave-like motion. It seems likely that the planaria's thickness relative to its length makes it more adapted for hydraulic motion, while the nematodes' long, thin shape makes it more adapted to slithering.
Next we looked at some preserved invertebrates in jars. These included an octopus, large spiders and worms, a bee, crabs, and several others.
Finally, we broke down our Burlese funnel and observed it. The funnel had been set up last week with a screen in the bottom and 500g of leaf litter from our transect on top. The idea was that the tiny invertebrates residing in the leaf litter would fall through the screen into a conical tube and be fixed in the 50:50 ethanol/water mixture for us to observe. The funnel was fit into the conical tube and wrapped with serafilm; we then attached this to a ring stand and left it standing under bright lights with everything covered in aluminum foil for one week. This week, we freed the conical tube, unwrapped the serafilm, and pipetted 15mL off the top of the mixture into a petri dish. We then poured the remaining 15mL of liquid into a second petri dish, and inspected both beneath a dissecting scope.
Data & Observations
The results from our Burlese funnel observations are detailed below. We were unable to locate any invertebrates in the top sample, and only found two in the bottom.
| Organism (phylum & class) | Length in mm | Number in sample | Description of organism | |
| Oribatid Mites | <1mm | 1 | Soil mite - brown/red body, short legs radiating from front of body, squashed teardrop shape | |
| Arthropoda Collembola | 3mm | 1 | Springtail X - flat, long segmented body, long curved antennae extending laterally from head | |
The picture below shows the springtail photographed through the dissecting scope.
Conclusions & Future Directions
While we expected to see more invertebrates in the samples from out Burlese funnel, we did get to observe the amazing diversity that occurs among arthropods. It is likely that if we had dug deeper or in a different area when collecting our leaf litter, we would have found many more specimens. We are currently in the process of collecting data on the larger invertebrates that inhabit our transect.
February 4, 2015:Plantae and Fungi
Purpose
The purpose of this lab today was to study the different characteristics of plants broadly and then more specifically to characterize the plant life occupying our transect. We also ran our PCR reactions to sequence the genes of the bacteria that we had collected the lab prior, to help us determine which species of bacteria had been living in our hay infusion. Finally, we loaded our leaf litter into the Burlese funnel to collect invertebrates for next lab.
Materials & Methods
First we loaded our DNA samples into the gel with the ladder and ran the PCR. When the DNA had travelled the majority of the length of the gel, we removed the gel and imaged it.
We viewed several samples of plants in the classroom, and then went to our transect to collect samples of five different plants and 500g of leaf litter to use in the Burlese funnel. We then returned to the lab and observed the plants collected, first with the naked eye and then with a microscope.
Finally, we set up the Burlese funnel. We filled a 50mL conical tube halfway with 50:50 ethanol/water solution and fitted a screen into the bottom of a funnel. We put the leaf litter we had collected into the funnel and inserted the bottom of the funnel into the conical tube, wrapped the funnel and tube in parafilm, and set this up on a ring stand under a 40 watt lamp, and covered everything in foil. Next week when we come back some invertebrates will have hopefully fallen into the ethanol preservative for us to observe.
Data & Observations
The picture below shows our results for the PCR. We had two samples loaded into the gel, but unfortunately, it appears that only one of our samples ran properly. The band on the left is the ladder, and the band on the right is our sample. I believe our gel might have benefitted from a slightly longer running time to make differentiation easier. From this it appears that the DNA sample was somewhere around 1.5 kilobases.
This table details the information gathered on the plants sampled from the transect:
| Transect Sample Plants | Location and # in transect | Description (size and shape) | Vascularization | Specialized Structures | Mechanisms of Reproduction |
| #1 | 1, south central section | Five-foot-high tree with thin brown branches & red berries | yes | berries | berries = ovaries |
| #2 | 30, surrounding flagstones | light green moss growing in 6-inch-wide patches (colonies) | no | spines sticking out in all directions, growing low to ground | water-dependent? |
| #3 | 2, behind bench (eastern section) | Grass about half an inch thick and a foot and a half long, green with striations | yes | noticable grain (rough if rubbed one way); monocot | seeding |
| #4 | 1, northeastern section | bush with thin, dark green leaves about 1 in. long & thing protruding branches | yes | leaves protruding in different directions for maximum sun exposure; monocot | seeding |
| #5 | 10, south central section | brown plant with wide curved leaves growing close to the ground | yes | growing along the ground = less weight to support | seeding |
Below are images of the plant samples we collected and where we obtained them:




We were not able to find any seeds, although two of our plants, the grass and the bush with long dark green leaves, fit the description of a monocot. We did not find evidence of any flowers or spores in any of our plants.
In observing the fungi, we focused on the sporangia, which are black, globe-like structures that when mature release spores for reproduction. The black bread mold we observed most likely belongs to the family ascomycota.
Conclusions & Future Directions
We now have data collected one five different plant species, which we will attempt to identify by name. Most of these plants had some type of vascularization, which meant that they could support more weight and thus grow up to obtain more sunlight. The Burlese funnel setup will be used next time to analyze some of our transect's resident invertebrates. We expect to see spiders and other, very small insects as there were none visible in the leaf litter as we were collecting it.
AT
January 28, 2015
Identifying Bacteria from the Hay Infusion
Purpose
One of the purposes of this lab was to give an overview of the basic characteristics of bacteria and archaea and the differences between then. Last week we had prepared plates with samples from our transect on tetracycline and non-tetracycline agar gel. We did not expect to see any archaea species growing on the plates because the transect did not provide extreme enough conditions (being a "wildlife habitat") as archaea typically dwell in.
Materials & Methods
First, we observed the colonies on the agar plates with the naked eye. We then prepared slides by taking samples from one colony on each plate, and examined them under the microscope. Later, samples from the same colony were stained with gram stain and the slides were then re-examined to determine whether the bacteria in question were gram positive or negative.
The gram stain was performed by using a sterile loop to collect part of a bacteria colony off of a plate and onto a slide with a drop of water. The slide was then air dried and heat fixed by passing it through a flame three times. It was covered with crystal violet for 1 minute, washed, and then covered with Gram's iodine mordant for 1 minute, then rinsed again. The smear was then decolorized by washing it with alcohol and then covered with safrinin stain. A kimwipe was used to dry the slide, and it was then observed under the microscope at 40x and under oil immersion at 100x.
One sample was collected from the antibiotic and non-antiobiotic treated plates for DNA isolation. For each of the two samples, the colonies were transferred to 100 uL of water in a small tube and incubated at 100 degrees C for 10 minutes. The samples were then centrifuged for 5 minutes. 20 uL of primer was added to two PCR tubes, and 5uL of the supernatant from the centrifuged tubes was added to each clearly labelled PCR tube, which were then placed into the PCR machine for next time.
Data & Observations

We noticed that blue colonies grew only on the non-antibiotic-treated plates. The colonies on the untreated plates were much more numerous, which was in line with expectations. The lower the dilution, the more bacteria per plate. The most dilute tet-treated plates contained no visible colonies. The gold-colored colonies seemed to thrive best on the least dilute tet-treated plate, but they did not survive the serial dilution. None of our plates contained any traces of fungi growth.
When we stained our bacteria samples, we were able to see them more clearly. as the gram stain had colored the peptidoglycan. The picture below is of the colony on the non-tet-treated plate at 10^-5 dilution at 100x in oil immersion.
When we made our last observation of our Hay Infusion, we noticed that a lot of the water had evaporated, and a lot of the solid plant matter seemed to have disintegrated, leaving mostly silt behind. The rotting odor was still present but was not nearly as strong. I would hypothesize that if we looked at samples under the microscope again this week, we might not see the diversity of life that we observed last week -- competition would have paved the way for certain organisms to dominate while others disappeared.
AT
January 21, 2015
In this lab we identified different strains of algae and protists, first from slides and then from our hay infusion. When we brought the hay infusion over to our work area, we could immediately smell a very strong organic odor. The water was cloudy, and had a thick, silvery skin formed on top of it. We did not notice anything else, such as mold, growing over the top.![]()


We obtained samples from two different locations within the jar and made wet mounts to examine under the microscope. The first sample came from the top of the water, just below the skin and beneath a twig that was sticking out of the water. Judging by the wet mount, this area seemed to be the less populated of the two. The first organism that we observed was a ovular, with circular green spots in the middle. It seemed to be somewhat bent, and was constantly spinning. Matt mentioned the possibility that the organism's flagella could be folded over itself and thus not visible. Based on most of its characteristics, it seems likely that this may have been a paramecium, although the fact that it appeared to contain chloroplasts would seem to counter this.
The next organism that we looked at appeared as a cluster of about 16 green spheres, probably colonies of smaller organisms, arranged in a single plane. This organism also appeared to be photosynthetic and was non-motile. Based on its appearance, I would guess that this was a Gonium, but it may also have been a Pandorina.
The second wet mount sample we took from the bottom, and this contained many more life forms. Brown algae was a big part of this environment. I would speculate that the brown algae provide protection as well as a food source for heterotrophic organisms, which may be why they are more attracted to the bottom of the infusion than the top. The first organism that caught our attention was moving very quickly and thus difficult to hold in the field of view for very long. It was shaped like an oval with a crescent-shaped indentation on one side. The water was moving very rapidly around it, which points to its having cilia even though they were not immediately visible. Because of its rapid motion, I would categorize this organism as a scavenger and thus a heterotroph. Based on these characteristics, it seemed to resemble a blepharisma.
As previously mentioned, brown algae made up a large part of the second wet mount. The average algae was a brown, furry-looking clump about 175 um in length and non-motile. Additionally, there were many round, green, oval-shaped organisms floating around in the water, about 2.5 um in length. These we classified as Chlamydomonas, as they shared all of the same characteristics of the organisms we had examined the previous week. Finally, we also discovered a Volvox, which was large (137.5 um), round, and green, largely transparent with tiny dots and three larger, darker round areas throughout.
The Volvox fits the five qualifications of life by...
Reproduction: reproduces oogamously, contains specialized reproductive cells (female gamete larger than the male)
Evolution: most complex in the Volvocine line, evolved from the simplest form Chlamydomonas and intermediate form Gonium
Information: each of the thousands of cells in the colony contain genetic information that direct their development as well as reproduction
Cells: composed of a colony of thousands of spiked cells displaying simple specialization (vegetative vs. reproductive)
Energy: cells contain chloroplasts which allow them to convert light energy into chemical energy via photosynthesis
If the hay infusion culture were to grow for another two more months, I would expect to see the algae population thrive and become more present in other areas of the jar. The algae seemed quite hardy and also seemed to have grown the most quickly based on size of any of the other photosynthetic organisms. I might expect this to mean competition for the other photosynthetic organisms, because the algae might eventually block out the light available due to its dark color. The increased presence of algae would also provide additional food for the heterotrophic organisms, which I expect would thrive in this environment.
After examining our two wet mounts under the microscope, we performed a serial dilution of the culture in growth medium, and then transferred 100 ul from each tube onto nutrient agar plates. The serial dilution process is detailed below.
AT
January 14, 2015
Very complete notebook! Thanks for including the volvocine information. Great description of the transect. ML
Today in lab we examined the concept of evolution, using three members of the Volvocine line as an example. Organisms in the Volvocine line belong to the green algae group, Chlorophyta. The three organisms that we viewed, ranging from least to most complex, were Chlamydomonas, Gonium, and Volvox. The chart below details observations collected on each genus.
We were assigned the wildlife habitat transect. The area is located on the northern part of campus next to the Hughes building. It is located on sloped ground and has several benches and flagstones for foot traffic. We photographed the transect, made note of biotic and abiotic elements inhabiting it, and then collected a sample of soil and surface matter to be use in a hay infusion. We took this back to the lab, added it to a jar with some distilled water and powdered milk, and left it sitting open on the counter.
Biotic elements: trees (3 varieties), grasses (3 varieties), mulch, moss, berries. Below is a map of the transect, as well as some photographs.
Abiotic elements: snow, flagstones, rocks, signs (2). 




AT
Test Post

AT